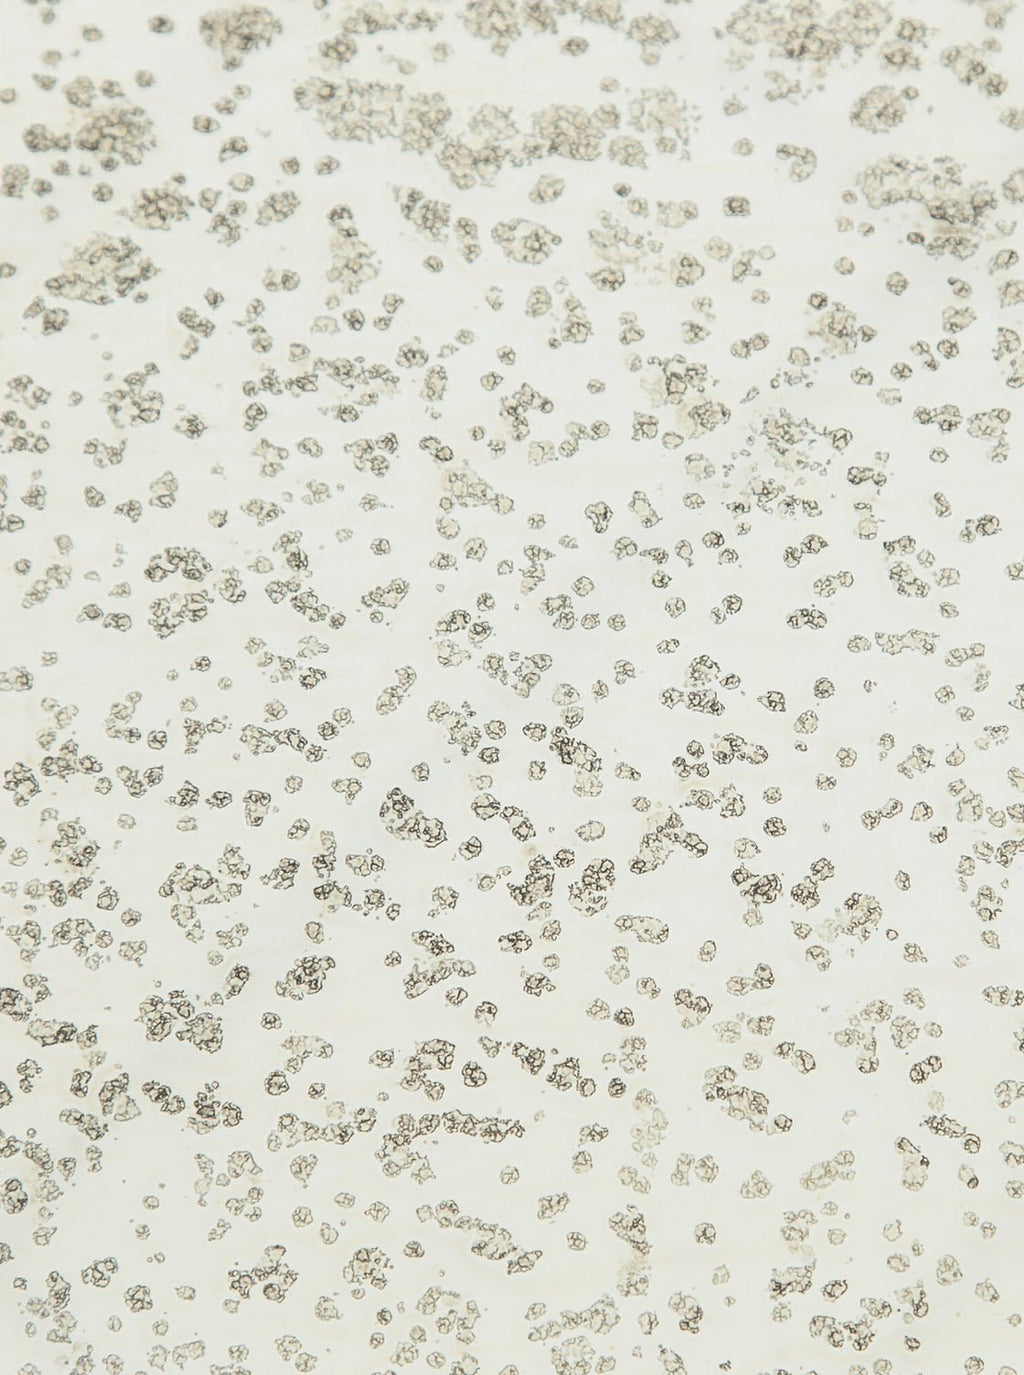
Table d'appoint Bridger

Passer aux informations sur le produit


Table d'appoint Bridger
€379,00
Le pied central de cette table dégage un charme vintage grâce à ses détails raffinés et sa silhouette classique, évoquant la nostalgie et un attrait intemporel. Associé à un plateau en verre cendré effet miroir, il confère à cette table une esthétique résolument moderne, offrant un contraste saisissant entre l'ancien et le nouveau.
*Les délais de livraison peuvent varier.
*Les dates de précommande sont susceptibles de changer.
Vous aimerez peut-être aussi